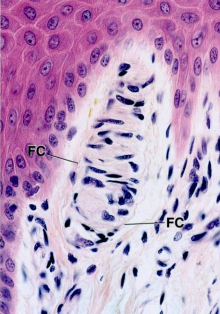

Meissner’s corpuscles - located in dermal papillae

HD - hemidesmosome, A - focal adhesion, B - basal cell, L - lamina lucida, D - lamina densa, C - collagen type III (reticular fibrils), F - anchoring fibrils, I - intermediate filaments

Stratum spinosum with cytoplasmic processes connected by desmosomes (at the light level called nodes of Bizzozero). Mitotically inactive, vitamin D production.

Hair follice with internal and external root sheath, glassy membrane, cortex labeled.

KG - keratohyalin granule in the stratum granulosum, the “grainy” third layer of the epidermis, involved in keratinization.

Basal Lamina - above Stratum Basale.

Langerhan’s Cell - note Birbeck granules (arrows), indented nucleus,and tonofilaments (T)

Melanocyte with melanin granules, surrounded by kerotinocytes

Reticular layer - Dermis. Dense irregular connective tissue, closely packedthick collagen fibers (type I), thick elastic fibers.

malignant melanoma - no desmosomes, so high potential for metastasis

Reticular layer - Dermis. Dense irregular connective tissue, closely packed thick collagen fibers (type I).

Eccrine sweat glands - Narrow lumen, ACh innervation. Widely distributed. Merocrine Secretion.

Stratum Corneum - the outermost layer of the epidermis, consisting of dead cells (corneocytes).
A barrier to protect underlying tissue from infection, dehydration, chemicals and mechanical stress. Desquamation, the process of cell shedding from the surface of the stratum corneum, balances proliferating keratinocytes that form in the stratum basale.

Melanocyte, cytoplasmic extensinos, and melanin granules


Pacinian Corpuscle - deep in integumen, deep vibration sensation

Stratum Spinosum. D - Desmosome. Desmosome lies within cytoplasmic extensions, anchoring SS to neighboring keratinocytes. Also has desmosomes (nodes of Bizzozero). Mitotically inactive.

Merkel cells - tactile, neural crest derived, located in stratum basale

Apocrine sweat glands - Wide lumen. Merocrine secretion. Protein-rich product. Adrenergic innervation. Axilla, anus, external genetalia.

rod-shaped Birbeck granules

Melanocytes with no discernable nucleus, unlike keratinocytes in stratum basale above.

Hair follice with extenral, internal root sheath labeled, cuticle, glassy membrane.
High magnification eccrine sweat gland with dark cells (D), clear cells (C ) adjacent to intercellular canaliculi (IC), and myoepthelial (My) cells that contract to assist in secretion.

Sebaceous gland. Branched acinar gland in hair follicle that uses holocrine secretion to secrete sebum.


